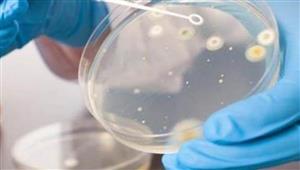
خبير يكشف قائمة الأمراض التي ظهرت في أوكرانيا

إعلان
-
07 أكتوبر, 2024
-
07 يونيو, 2022
-
13 مارس, 2022
-
08 مارس, 2022
-
05 مارس, 2022
-
01 مارس, 2022
-
26 فبراير, 2022
-
26 فبراير, 2022
-
01 مايو, 2020
-
21 يوليو, 2019
-
05 سبتمبر, 2018
-
11 يوليو, 2016
-
إعلان
-
03 ديسمبر, 2014
إعلان
إعلان